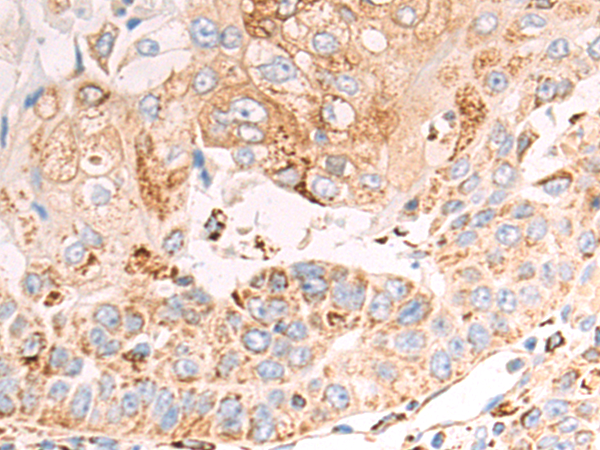
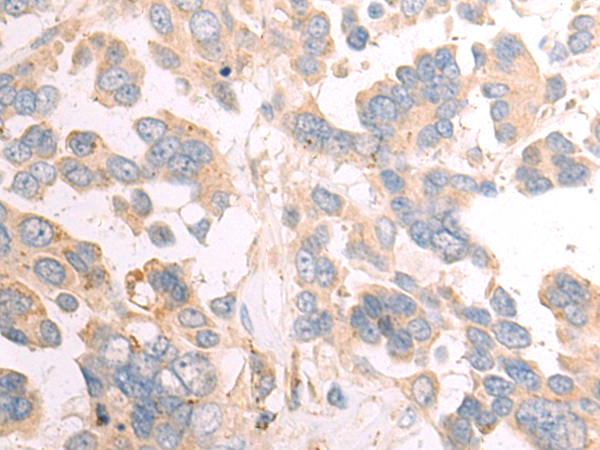

-
分类: 科研抗体货号: P09747别名: EIF2; EIF2G; MRXSBRK; eIF-2gA; EIF2gamma应用: IHC反应种属: Human, Rat
-
分类: 科研抗体货号: P09731别名: SQR; SQRDL; CGI-44; PRO1975应用: WB,IHC反应种属: Human, Mouse
-
分类: 科研抗体货号: P09746别名: PCTK3; PCTAIRE; PCTAIRE3应用: WB反应种属: Human, Mouse, Rat
-
分类: 科研抗体货号: P09730别名: IFNA; IFNA2B; leIF A; IFN-alphaA; IFN-alpha-2应用: WB,IHC反应种属: Human, Mouse
-
分类: 科研抗体货号: P09745别名: OMP85; SAM50; TOB55; TRG-3; CGI-51; YNL026W应用: IHC反应种属: Human, Mouse, Rat
-
分类: 科研抗体货号: P09728别名: BDA2; BMP2A; SSFSC; SSFSC1应用: WB,IHC反应种属: Human, Mouse, Rat
-
分类: 科研抗体货号: P09744别名: PARIS1; PARIS-1; TBC1D2A应用: IHC反应种属: Human, Mouse, Rat
-
分类: 科研抗体货号: P09723别名: AIS; KET; LMS; NBP; RHS; p40; p51; p63; EEC3; OFC8; p73H; p73L; SHFM4; TP53L; TP73L; p53CP; TP53CP; B(p51A); B(p51B)应用: WB,IHC反应种属: Human, Mouse, Rat
-
分类: 科研抗体货号: P09721别名: RABGDIB; HEL-S-46e应用: WB,IHC反应种属: Human, Mouse, Rat
-
分类: 科研抗体货号: P09743别名: ZNF-X; ZBTB22B; ZNF297B应用: WB,IHC反应种属: Human, Mouse

鄂公网安备42018502007531号
鄂公网安备42018502007531号

